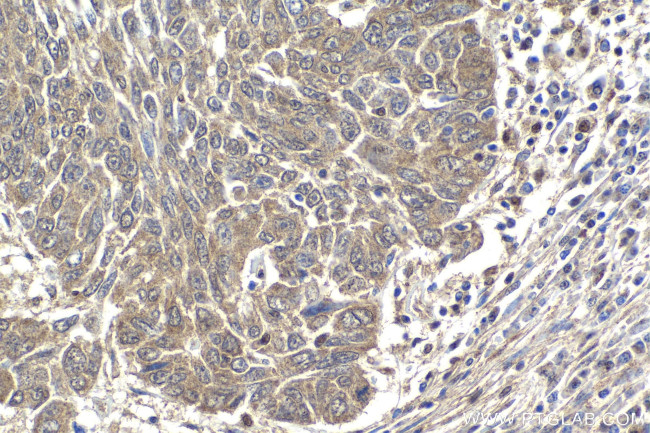
SMURF2 Antibody in Immunohistochemistry (Paraffin) (IHC (P))

Search
Proteintech
SMURF2 Polyclonal Antibody
{{$productOrderCtrl.translations['antibody.pdp.commerceCard.promotion.promotions']}}
{{$productOrderCtrl.translations['antibody.pdp.commerceCard.promotion.viewpromo']}}
{{$productOrderCtrl.translations['antibody.pdp.commerceCard.promotion.promocode']}}: {{promo.promoCode}} {{promo.promoTitle}} {{promo.promoDescription}}. {{$productOrderCtrl.translations['antibody.pdp.commerceCard.promotion.learnmore']}}
产品信息
18038-1-AP
种属反应
宿主/亚型
分类
类型
抗原
偶联物
形式
纯化类型
保存液
内含物
保存条件
运输条件
产品详细信息
Immunogen sequence: AGHCRIEVSR EEIFEESYRQ VMKMRPKDLW KRLMIKFRGE EGLDYGGVAR EWLYLLSHEM LNPYYGLFQY SRDDIYTLQI NPDSAVNPEH LSYFHFVGRI MGMAVFHGHY IDGGFTLPFY KQLLGKSITL DDMELVDPDL HNSLVWILEN DITGVLDHTF CVEHNAYGEI IQHELKPNGK SIPVNEENKK EYVRLYVNWR FLRGIEAQFL ALQKGFNEVI PQHLLKTFDE KELELIICGL GKIDVNDWKV NTRLKHCTPD SNIVKWFWKA VEFFDEERRA RLLQFVTGSS RVPLQGFKAL QGAAGPRLFT IHQIDACTNN LPKAHTCFNR IDIPPYESYE KLYEKLLTAI EETCGFAVE
靶标信息
SMURF2 is an E3 ubiquitin-protein ligase which accepts ubiquitin from an E2 ubiquitin-conjugating enzyme in the form of a thioester and then directly transfers the ubiquitin to targeted substrates. This protein interacts with SMAD1, SMAD2 and SMAD7 in order to trigger their ubiquitination and proteasome-dependent degradation. It enhances the inhibitory activity of SMAD7 and reduces the transcriptional activity of SMAD2. Coexpression of SMURF2 with SMAD1 results in considerable decrease in steady-state level of SMAD1 protein and a smaller decrease of SMAD2 level.
仅用于科研。不用于诊断过程。未经明确授权不得转售。
篇参考文献 (0)
生物信息学
蛋白别名: E3 ubiquitin ligase SMURF2; E3 ubiquitin-protein ligase SMURF2; HECT-type E3 ubiquitin transferase SMURF2; hSMURF2; SMAD ubiquitination regulatory factor 2; SMAD-specific E3 ubiquitin-protein ligase 2
基因别名: 2810411E22Rik; AI558114; AI649275; RGD1310067; SMURF2
UniProt ID: (Human) Q9HAU4, (Mouse) A2A5Z6
Entrez Gene ID: (Human) 64750, (Rat) 303614, (Mouse) 66313